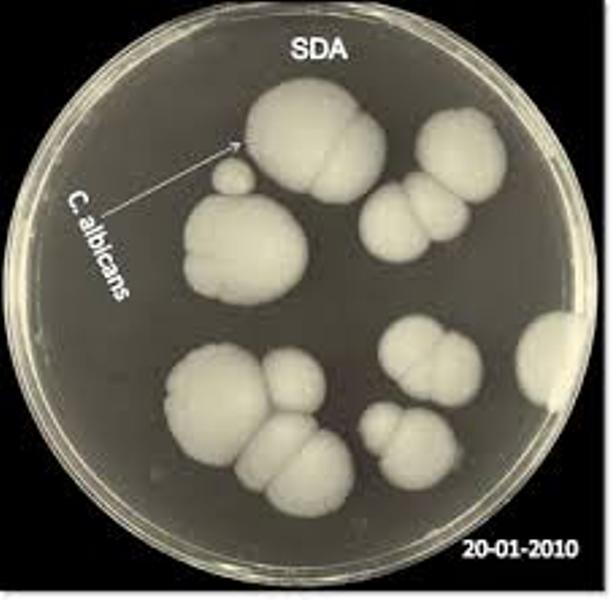
images-18

*γυναικολόγου, medlabnews.gr
Είναι γεγονός ότι τους καλοκαιρινούς μήνες, οι γυναίκες ταλαιπωρούνται συχνά από κολπίτιδες, οι οποίες εκδηλώνονται με ενοχλητικά συμπτώματα, που επηρεάζουν την ποιότητα της καθημερινής τους ζωής.
Το καλοκαίρι δεν μας αφήνει μόνο μαύρισμα και αναμνήσεις αλλά και ευκαιριακές λοιμώξεις. Οι περισσότερες γυναίκες κάνουν τον ετήσιο γυναικολογικό τους έλεγχο το Σεπτέμβρη προκειμένου να διαγνωστούν τυχόν προβλήματα που δεν έχουν εμφανίσει ιδιαίτερα συμπτώματα.
Η μυκητιασική κολπίτιδα αποτελεί το 20% περίπου των κολπίτιδων. Ειδικά το καλοκαίρι, η συχνότητα των μυκητιάσεων είναι ακόμα μεγαλύτερη, αφού η ζέστη και η τοπική υγρασία που αυξάνεται από την έντονη εφίδρωση, είναι παράγοντες που ευνοούν την υπερανάπτυξη των μυκήτων.
H ζεστή άμμος της θάλασσας περιέχει μικροοργανισμούς (μύκητες, παράσιτα, κόκκους), οι οποίοι μπορεί να προέρχονται από ούρηση και αφόδευση ζώων (σκύλοι, γάτες, πουλιά), που μπορεί να μεταφερθούν στα εξωτερικά και εσωτερικά όργανα της γυναίκας με άσχημες συνέπειες.
Οι μυκητιασικές κολπίτιδες οφείλονται συνήθως στον μύκητα Candida albicans. Η τοπικά αυξημένη υγρασία και η θερμοκρασία του καλοκαιριού δημιουργούν ευνοϊκές συνθήκες για ανάπτυξη κολπικής μυκητίασης.
Είναι λανθασμένη η εντύπωση ότι οι γυναίκες ‘κολλούν’ τους μύκητες από τη θάλασσα. Για να συμβεί αυτό θα πρέπει η περιοχή όπου κολυμπούν να είναι πολύ μολυσμένη, ουσιαστικά δηλαδή να απαγορεύεται η κολύμβηση. Υπάρχουν βέβαια και συνθήκες που ευνοούν την ανάπτυξη μυκήτων, όπως η λήψη αντιβιοτικών ή αντισυλληπτικών.

Πώς θα τις προλάβετε;
-Ακολουθείτε τους κανόνες υγιεινής, αποφεύγοντας την χρήση αντισηπτικών και κολπικών πλύσεων (χωρίς ιατρική οδηγία).
-Αποφεύγετε τα συνθετικά εσώρουχα, τα πολύ στενά παντελόνια και τα σερβιετάκια.Καλό είναι να φοράτε βαμβακερά εσώρουχα και να αποφεύγετε τα συνθετικά που ευνοούν την υγρασία λόγω ιδρώτα.
-Βεβαιωθείτε ότι οι πετσέτες του μπάνιου που χρησιμοποιείτε είναι προσωπικές και ότι αλλάζονται συχνά
-Διατηρείτε την υγιεινή της περιοχής με τοπικές πλύσεις με χαμομήλι, αποφεύγοντας τα αφρόλουτρα ή τα αντισηπτικά προϊόντα που πιθανόν να αλλάξουν το pΗ της ευαίσθητης περιοχής σας.
-Στην παραλία χρησιμοποιούμε πάντα πετσέτα και δεν καθόμαστε πάνω στην άμμο ή την ξαπλώστρα απευθείας.
-Κάνετε ντους τουλάχιστον σε καθημερινή βάση και ιδιαίτερα μετά το κολύμπι και την παραλία.
-Επιλέγουμε καθαρές θάλασσες και πισίνες για το μπάνιο μας. Πολλά μικρόβια μπορεί να μεταφερθούν από τα μολυσμένα νερά τους.
-Αν κολυμπάτε σε πισίνα, κάνετε ντους επιμελώς πριν ντυθείτε, ώστε να απαλλαγείτε από το χλωριωμένο νερό και ανεπιθύμητα μικρόβια.
-Αλλάζετε το βρεγμένο μαγιό με στεγνό.
-Διατροφή πλούσια σε φρούτα, λαχανικά και γιαούρτι θωρακίζει την άμυνα του οργανισμού.
-Σιδερώνετε τα εσώρουχα σας.
-Αν και η χρήση ταμπόν μπορεί να σας εξασφαλίσει μερικές παραπάνω μέρες στην παραλία, αποφεύγετε το κολύμπι όταν η ροή της περιόδου είναι μεγάλη και αλλάζετε τα ταμπόν συχνότερα από ότι συνήθως.
-Δεν ξεχνάμε να χρησιμοποιούμε προφυλακτικό στις σεξουαλικές μας επαφές.






























